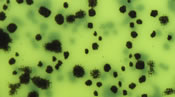
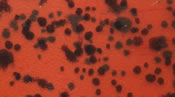
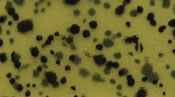

Skirts Plus Colors
Below are categories of our colors available. Just click on the title for that set and it will expand to show you our samples. Click the title again to close that section.
NEW! KT-1 |
NEW! KT-2 |
NEW! KT-3 |
NEW! KT-4 |
NEW! KT-5 |
NEW! KT-6 |
NEW! KT-7 |
NEW! KT-8 |
NEW! KT-9 |
NEW! KT-10 |
NEW! KT-11 |
NEW! KT-12 |
NEW! KT-13 |
NEW! KT-14 |
NEW! KT-15 |
NEW! KT-16 |
NEW! KT-17 |
NEW! KT-18 |
NEW! KT-19 |
NEW! KT-20 |
NEW! KT-21 |
NEW! KT-22 |
NEW! KT-23 |
NEW! KT-24 |
NEW! KT-25 |
NEW! KT-26 |
NEW! KT-27 |
NEW! KT-28 |
NEW! GL-1 |
NEW! GL-2 |
NEW! GL-3 |
NEW! GL-4 |
SG-101 |
SG-102 |
SG-107 |
SG-108 |
SG-110 |
SG-116 |
SG-117 |
SG-118 |
SG-119 |
SG-120 |
SG-121 |
SG-122 |
SG-123 |
SG-125 |
SG-126 |
SG-127 |
SG-131 |
SG-133 |
SG-134 |
SG-135 |
SG-136 |
SG-137 |
SG-138 |
SG-139 |
SG-140 |
SG-141 |
SG-142 |
SG-143 |
SG-144 |
SG-147 |
SG-149 |
SG-151 |
SG-152 |
SG-154 |
SG-156 |
SG-157 |
SG-158 |
SG-159 |
SG-161 |
SG-162 |
SG-164 |
SG-165 |
SG-166 |
SG-168 |
SG-171 |
SG-172 |
SG-173 |
SG-174 |
SG-177 |
SG-178 |
SG-179 |
SG-180 |
SG-181 |
SG-182 |
SG-183 |
SG-184 |
SG-185 |
SG-186 |
SG-189 |
SG-190 |
SG-191 |
SG-192 |
SG-193 |
SG-194 |
SG-195 |
SG-196 |
SG-197 |
SG-198 |
SG-500 |
SG-501 |
SG-502 |
SG-503 |
SG-504 |
SG-505 |
SG-506 |
SG-507 |
SG-508 |
SG-509 |
SG-510 |
NEW! SG-511 |
FG-201 |
FG-202 |
FG-203 |
FG-204 |
FG-205 |
FG-206 |
FG-207 |
FG-210 |
FG-211 |
FG-212 |
FG-215 |
FG-223 |
FG-224 |
FG-225 |
FG-228 |
FG-229 |
FG-233 |
FG-234 |
FG-235 |
FG-236 |
FG-237 |
FG-238 |
FG-239 |
FG-240 |
FG-241 |
FG-244 |
FG-245 |
FT-301 |
FT-305 |
FT-306 |
FT-307 |
FT-308 |
FT-309 |
FT-313 |
FT-314 |
FT-315 |
FT-317 |
FT-319 |
M-400 |
M-401 |
M-403 |
M-405 |
M-406 |
M-407 |
M-408 |
M-410 |
M-414 |
|
|
|
P-601 |
P-602 |
P-603 |
P-604 |
P-605 |
P-606 |
P-607 |
P-608 |
P-609 |
P-611 |
P-612 |
P-613 |
P-614 |
P-615 |
P-616 |
P-617 |
P-618 |
|
|
NPT-1 |
NPT-2 |
NPT-3 |
NPT-4 |
NPT-5 |
NPT-6 |
NPT-7 |
NE-701 |
NE-702 |
NE-703 |
NE-704 |
NE-705 |
NE-706 |
NE-707 |
NE-708 |
NE-709 |
NE-710 |
NE-711 |
NE-712 |
NE-713 |
NE-714 |
NE-715 |
NE-716 |
NE-717 |
NE-718 |
NE-719 |
NE-720 |
NE-721 |
NE-722 |
NS-901 |
NS-902 |
NS-903 |
NS-904 |
NS-905 |
NS-906 |
NS-907 |
NS-908 |
NS-909 |
NS-910 |
NS-911 |
NS-912 |
NS-913 |
NS-914 |
NS-915 |
NS-916 |
NS-917 |
NS-918 |
NS-919 |
NS-920 |
BW-1 |
BW-2 |
BW-3 |
BW-4 |
BW-5 |
BW-6 |
BW-7 |
BW-8 |
BW-9 |
BW-10 |
BW-11 |
BW-12 |
BW-13 |
BW-14 |
BW-15 |
BW-16 |
BW-17 |
BW-18 |
BW-19 |
BW-20 |
BW-21 |
BW-22 |
NEW! BW-23 |
BS-721 |
BS-722 |
BS-723 |
TT-721 |
|
|
|
ST-801 |
ST-802 |
ST-803 |
ST-804 |
ST-805 |
ST-806 |
ST-807 |
ST-808 |
ST-809 |
ST-810 |
ST-811 |
ST-812 |
ST-813 |
ST-814 |
ST-815 |
ST-816 |
ST-817 |
ST-818 |
ST-819 |
ST-820 |
801-A |
801-B |
801-D |
801-E |
801-G |
801-H |
802-A |
802-G |
804-A |
804-G |
805-I |
805-K |
806-B |
807-B |
807-M |
808-E |
811-E |
812-D |
817-A |
818-D |
CL-1 |
CL-2 |
CL-3 |
CL-4 |
CL-5 |
CL-6 |
CL-7 |
CL-8 |
CL-9 |
|
|
|
UT-1 |
UT-2 |
UT-3 |
UT-4 |
UT-5 |
UT-6 |
UT-7 |
UT-8 |
UT-9 |
UT-10 |
UT-11 |
UT-12 |
ZM-1 |
ZM-2 |
ZM-3 |
ZM-4 |
ZM-5 |
ZM-6 |
ZM-7 |
ZM-8 |
ZM-9 |
ZM-10 |
ZM-11 |
ZM-12 |
ZM-13 |
ZM-14 |
ZM-15 |
ZM-16 |
ZM-17 |
ZM-18 |
NEW! ZM-19 |
NEW! ZM-20 |